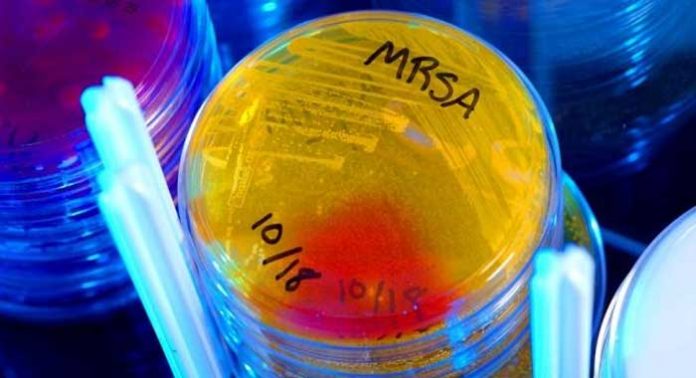

La carrera para encontrar nuevos tratamientos contra el SARM mortal tiene un nuevo competidor en la forma de un fármaco experimental que trata con éxito las infecciones de las bacterias resistentes a los fármacos en animales. El compuesto, llamado TXA709, también restauró la eficacia de cefdinir – un antibiótico utilizado durante casi 20 años que había perdido su capacidad para hacer frente al SARM.
Este fue el resultado de un nuevo estudio dirigido por la Universidad de Rutgers en Piscataway, Nueva Jersey, y publicado en la revista Agentes Antimicrobianos y Quimioterapia.
El Staphylococcus aureus resistente a la meticilina o SARM es una cepa de la bacteria Staphylococcus aureus que se ha vuelto resistente a varios antibióticos, primero a la penicilina en 1947, y luego a la meticilina, incuso hoy en día, una nueva cepa ha desarrollado resistencia a la vancomicina (SARV), uno de los pocos antibióticos que todavía eran capaces de controlar esta bacteria.
El autor principal de este estudio, Daniel Pilch, profesor asociado de farmacología en la Facultad de Medicina de Rutgers Robert Wood Johnson, explica la importancia del hallazgo:
«Esto es importante porque a pesar de que el TXA709 es eficaz por sí solo en el tratamiento del SARM, combinándolo con cefdinir – se usa para tratar una amplia gama de infecciones bacterianas como la faringitis estreptocócica, neumonía, bronquitis y el oído medio e infecciones de los senos paranasales – hace que sea aún más eficaz , al tiempo que reduce significativamente el potencial de que la bacteria SARM se vuelva resistente en el futuro».
Las infecciones por resistencia a la meticilina por Staphylococcus aureus (SARM) son responsables de miles de muertes en los hospitales estadounidenses cada año, y cuestan miles de millones de dólares de la economía.
La amenaza de estos y otros patógenos resistentes a los fármacos es tan grande que la Organización Mundial de la Salud (OMS) predice que las infecciones comunes y lesiones menores podrían llegar a ser peligrosas para la vida, debido a la falta de tratamientos eficaces.
Según la OMS, las personas con SARM se estima que cuentan con el 64% más de probabilidades de morir que las personas con una forma no resistente de la infección.
El mes pasado, los Centros para el Control y la Prevención de Enfermedades (CDC) reportaron el primer caso en los Estados Unidos de un paciente con una infección resistente al «último recurso» de antibiótico llamado colistina, cuya información será mejor detallada al final de este post.
SARM mata de una manera que no se observó antes
En su estudio, donde prueban el nuevo compuesto en ratones infectados, el Prof. Pilch y sus colegas, encuentran que TXA709 «retiene una potente actividad bactericida contra las cepas de S. aureus resistentes a los fármacos actuales estándar de atención, como vancomicina, daptomicina y linezolid.»
Señalan que el nuevo medicamento mata las bacterias del SARM de una manera que no se observa en los antibióticos que se utilizan actualmente. Bloquea una proteína llamada FtsZ, sin la cual la bacteria no puede dividirse y sobrevivir.
Otras pruebas demostraron que el fármaco demuestra una mínima toxicidad para las células de mamíferos, añaden.
Mediante la combinación de la nueva droga con cefdinir, un antibiótico de cefalosporina que actúa de manera similar a la penicilina, los investigadores fueron capaces de reducir la dosis de TXA709 necesaria para erradicar la infección por SARM.
El efecto de la combinación es un hallazgo importante, dicen, ya que reduce la posibilidad de efectos secundarios adversos que pudieran ocurrir a dosis más altas.
El equipo también observa que a medida que ambos medicamentos pueden tomarse por vía oral, se podría administrar por un ambulatorio. Esto es una ventaja ya que la mayoría de los tratamientos actuales contra el SARM tienen que administrarse por vía intravenosa y, obviamente, el ingreso del paciente en un hospital, lo que implica en la utilización de recursos que, por otro lado, serían utilizados a otros fines.
El Prof. Daniel Pilch llega a la conclusión de que:
«Actuales medicamentos estándar de atención para el tratamiento de las infecciones por SARM son limitados. Además, la resistencia a estos fármacos está en aumento, y su eficacia clínica es probable que disminuya en el futuro.»
Se han previsto ensayos de fase I del antibiótico experimental para la próxima primavera, dice el equipo. Estos procurarán evaluar su eficacia en humanos.
Medical Press ha informado en aquella ocasión sobre el primer caso en los EE.UU., de un paciente con una infección resistente al «último recurso» de antibiótico llamado colistina, y los detalles reportados se encuentran en este seguimiento:
La resistencia bacteriana a los antibióticos de último recurso






